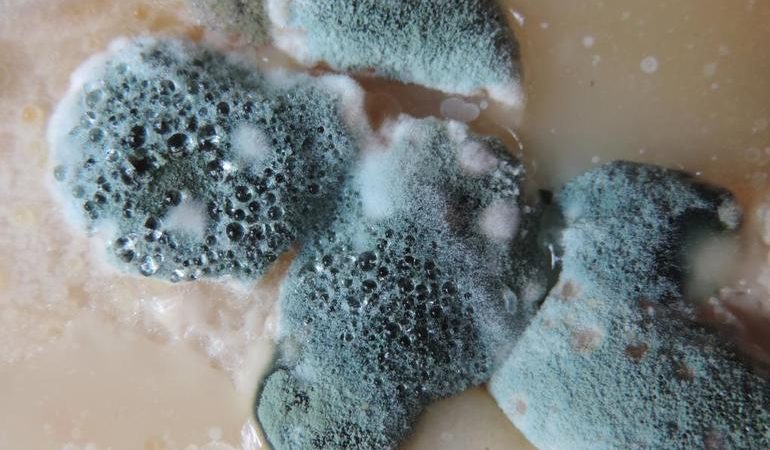
Значення, до чого сниться цвіль: трактування по сонникам, якщо бачити грибок на продуктах або стінах

До чого сниться крісло по сонникам Тлумачення сновидінь допомагає людям отримати відповіді на важливі питання, уникнути неприємностей, краще зрозуміти…
Що значить фотографуватися у сні: тлумачення сонників Зі сну образи часто виступають відображенням емоційного стану людини або вказують на…
Сонник до чого сниться цвіль на стінах і продуктах Деякі сни дивують дивними сюжетами. Зазвичай вони відображають внутрішні переживання…
Значення сновидіння про вазу з різних сонникам Всі здібності людини потрібні для чогось, у тому числі можливість бачити сни….
Примирення з колишнім хлопцем: до чого сниться сон про минулі відносини Сварка з близькою людиною є травматичним подією для…
Бачити уві сні яскраве сонце: тлумачення з різних сонникам Небесне світило — це символ влади, який у різних релігіях…
До чого сниться поранена собака, якщо звертатися до соннику На розуміння того, до чого сниться поранена собака, впливає кілька…
Сни, де сняться уколи: тлумачення по сонникам У кожному сні приховані символи і знаки. Вони попереджають сплячого про події…
Підказки з сонників про пострілах Чимало людей схильні вірити в те, що сни здатні допомогти знайти правильну лінію поведінки…
Тлумачення по сонникам сну, де довелося годувати грудьми кошеня Пухнасті кошенята зазвичай асоціюються з приємними емоціями — щастям, спокоєм,…